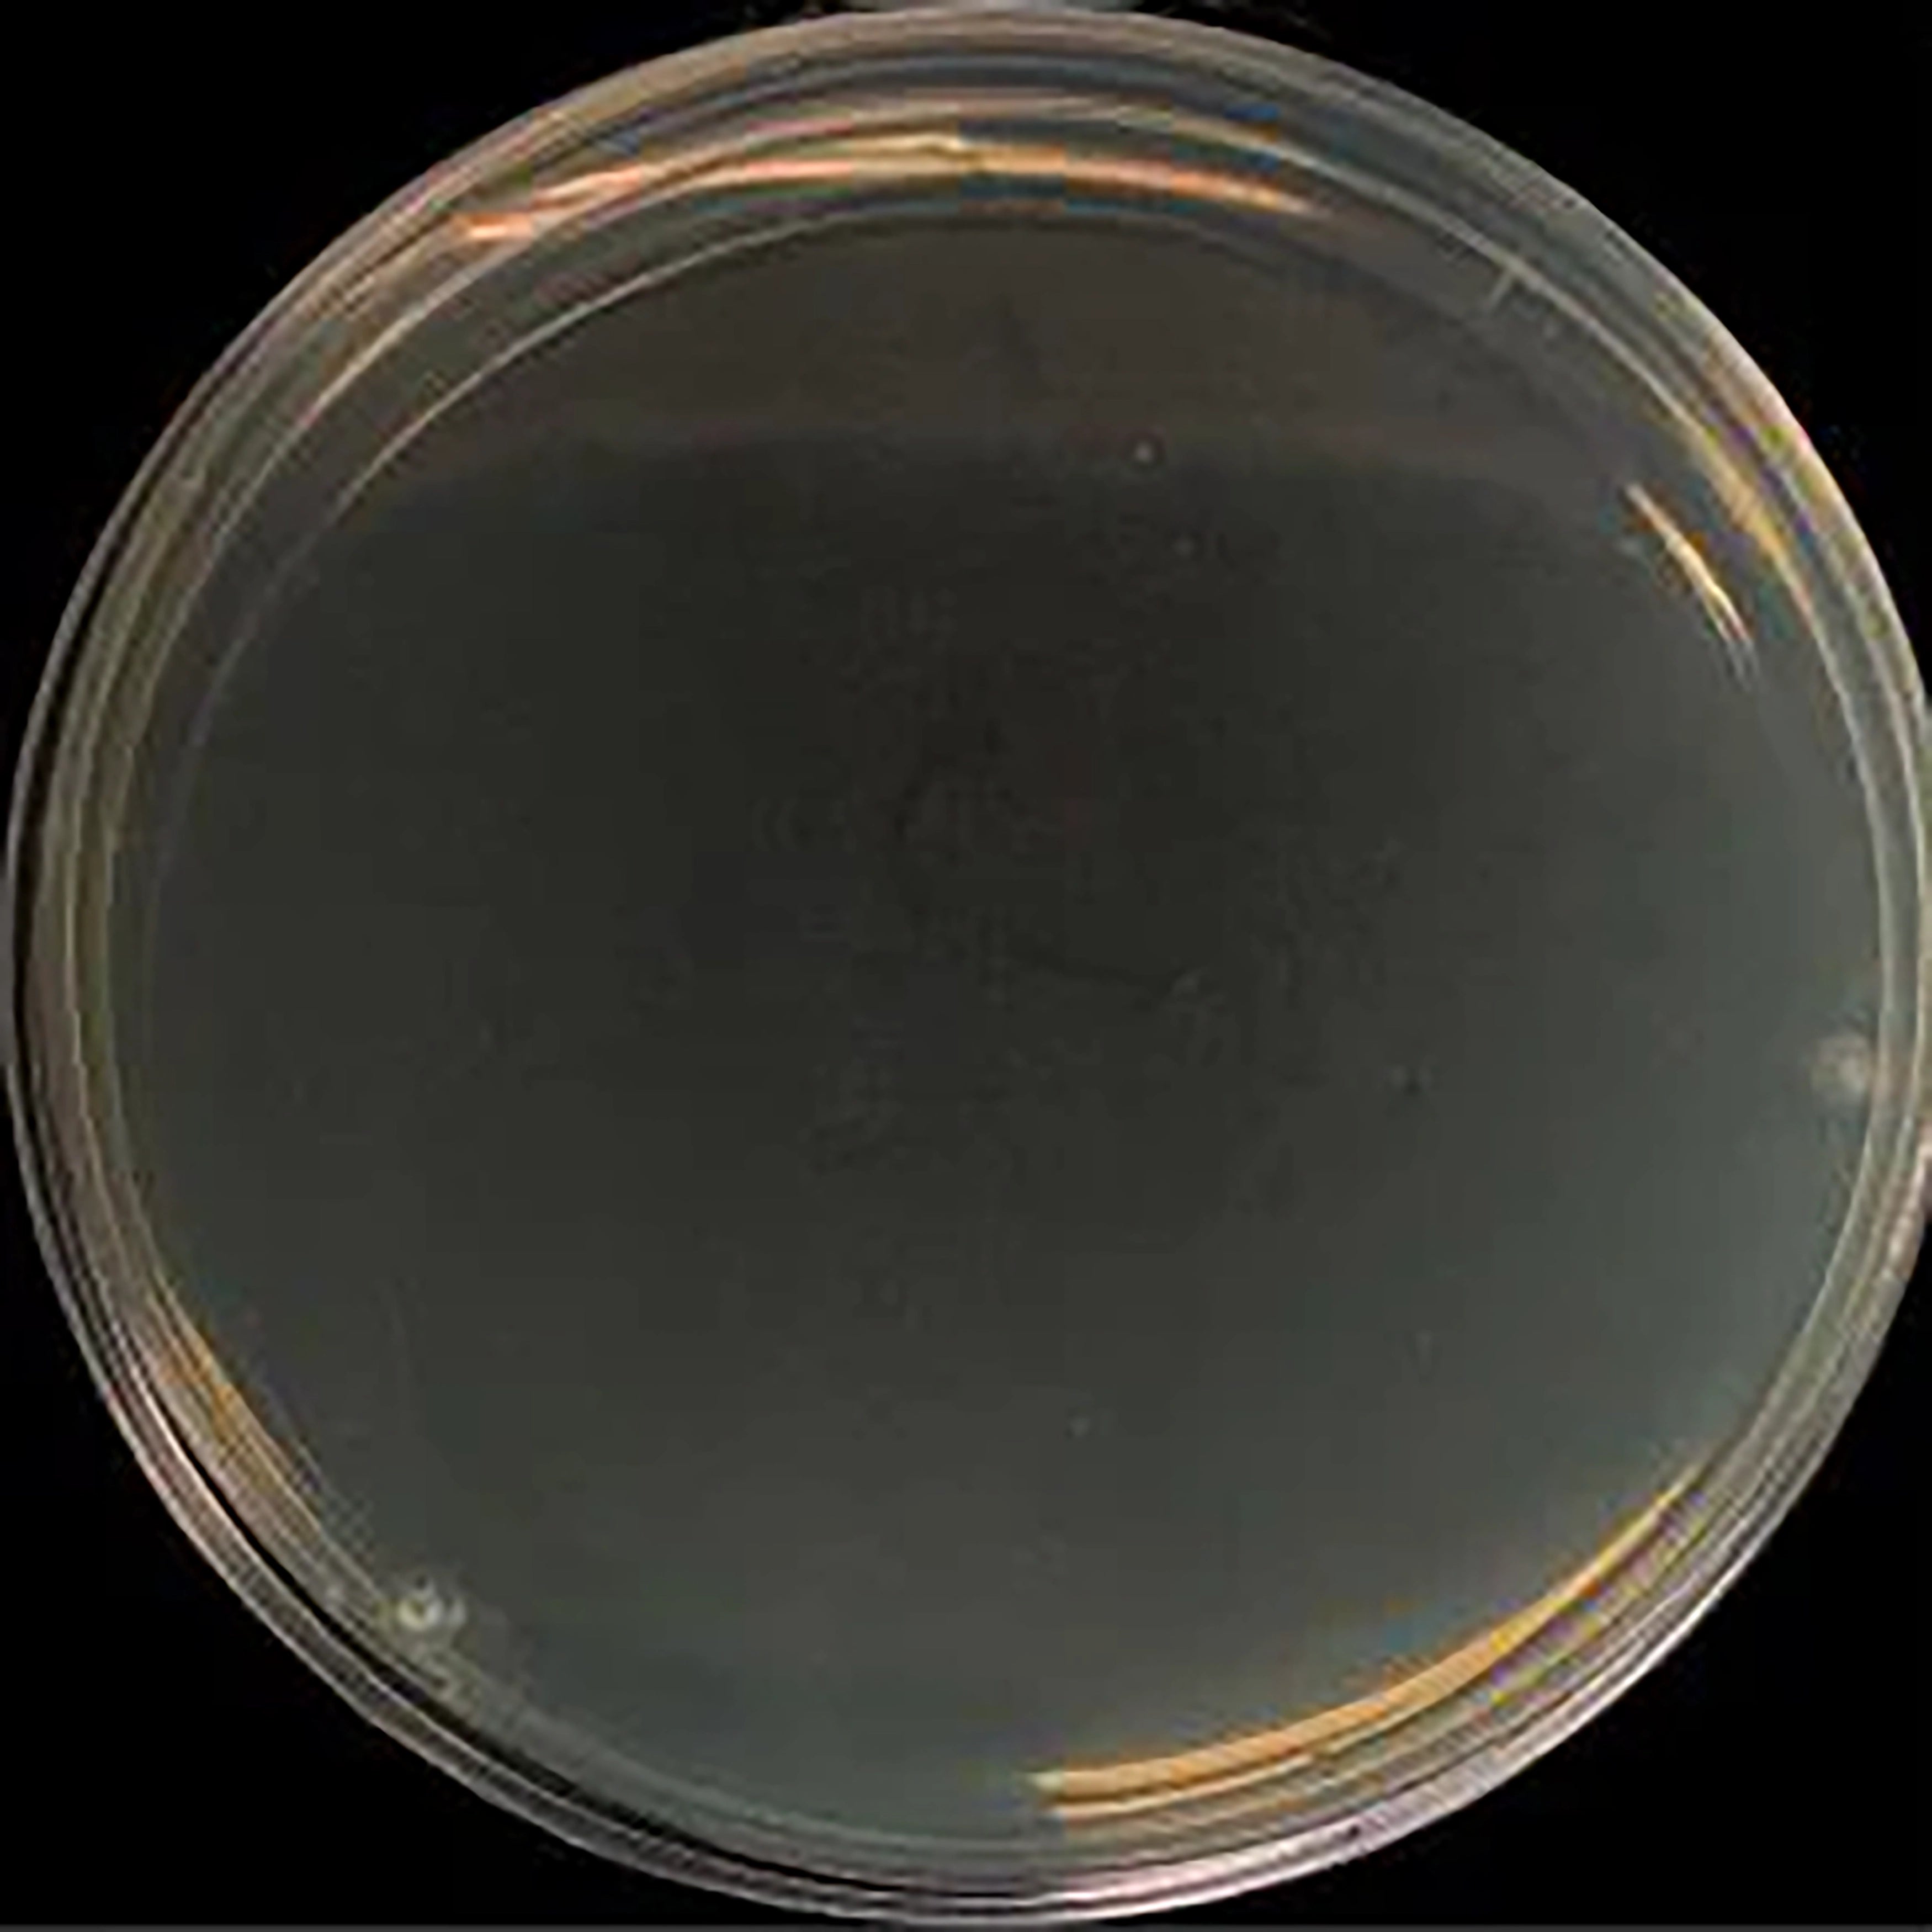

Медицинская промышленность
Мы работаем с профессиональными производителями медицинских изделий, чтобы поставлять компоненты для широкого спектра медицинских изделий, включая точное хирургическое оборудование, телемедицинские устройства, диагностическое оборудование и стоматологическое оборудование. Эти компании работают с XY-GLOBAL, потому что мы обеспечиваем им необходимую функциональную точность и гибкость, необходимую разработчикам медицинских и стоматологических устройств для инноваций и оптимизации своей продукции.
Медицинские тематические исследования

Эндоскопические устройства
Наш опыт в литье металлов под давлением (MIM) позволяет нам производить индивидуальные высокоточные эндоскопические устройства, которые отвечают строгим требованиям медицинской промышленности. Мы поставляем сложные биосовместимые компоненты для лапароскопических инструментов с допусками до ±0,001 мм.
Наши производственные возможности гарантируют стабильное качество и надежность, позволяя производителям медицинских приборов внедрять инновации и оптимизировать свою продукцию. От консультаций по проектированию до массового производства мы стремимся поддерживать разработку передовых медицинских решений.

Роботизированные хирургические инструменты
Наша передовая технология литья металлов под давлением (MIM) позволяет производить роботизированные хирургические инструменты с исключительной точностью и надежностью.
Мы специализируемся на производстве сложных биосовместимых компонентов, отвечающих строгим требованиям современных роботизированных хирургических систем.
От сложного проектирования до серийного производства — наши решения поддерживают инновации и производительность роботизированных хирургических инструментов нового поколения.

Анализаторы для биологических наук
Мы стремимся поддерживать отрасль наук о жизни с помощью точного производства, которое отвечает самым строгим требованиям. Наша сертификация ISO 13485 гарантирует соответствие медицинским стандартам, гарантируя надежность и безопасность продукции.
Благодаря контролируемой производственной среде и современному оборудованию мы поставляем биосовместимые, высокоточные компоненты, соответствующие требованиям наук о жизни и медицинских технологий.
Хирургические инструменты
Биосовместимые медицинские изделия
Обработка поверхности медицинских имплантатов

Сертифицировано по ISO 13485:2016
XY-global, как надежный поставщик деталей для медицинского оборудования, имеет сертификат ISO 13485, стандарт системы менеджмента для производства медицинских устройств. Это демонстрирует, что все прототипы и компоненты медицинских устройств, которые вы получаете от нас, соответствуют всем нормативным требованиям. Это также подчеркивает нашу надежную систему контроля и обеспечения качества, гарантируя вам, что мы изготовим компоненты, которые будут соответствовать вашим конкретным потребностям. Мы готовы обслуживать каждого клиента в области стоматологического и хирургического оборудования, биотехнологий и многого другого!
Антибактериальная нержавеющая сталь
MIM Supplier использует нержавеющую сталь 316L, содержащую серебро, изготовленную методом порошковой металлургии, для решения инженерной проблемы несовместимости серебра и железа. Микроструктура показывает, что наночастицы серебра равномерно распределены в матрице нержавеющей стали, что обеспечивает хорошие антибактериальные свойства широкого спектра действия.

Точное производство для медицинского совершенства
С командой опытных инженеров мы предоставляем комплексную техническую поддержку и послепродажное обслуживание для решения любых проблем во время использования. Кроме того, мы обеспечиваем полную прослеживаемость на протяжении всего процесса литья под давлением металла или керамики, предоставляя подтверждение происхождения (COA) и подробные записи для каждого этапа производства.